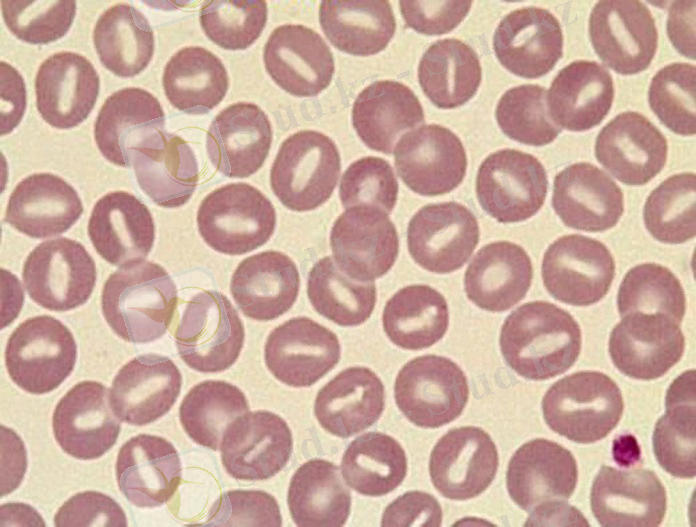
http://vrachfree.com/images/bolezni/gipervolemiya.jpg

Қоян өнімдерін жұқпалы емес аурулар кезіндегі ветеринариялық-санитариялық сараптау


Қазакстан Республикасының Білім және Ғылым Министрлігі
Семей қаласының Шәкәрім атындағы Мемлекеттік университеті
Ветеринариялық санитария кафедрасы
БӨЖ
Тақырыбы: Қоян шаруашылығы өнімдерін жұқпалы емес аурулар кезінде ветеринариялық-санитариялық сараптау.
Орындаушы: Ануарбекова А. А
Тексеруші: Сүлейменов Ш. Қ.
Топ: ВС-203
2015 жыл
Жоспар
Кіріспе
І Негізгі бөлім
Өнімдерді ветеринариялық-санитариялық сарапау
- Жарақаттар.
- Арықтау (жүдеу) .
- Абсцесстер, флегмоналар, іріңді жаралар.
- Гидремия.
- Уремия.
- Сары ауру.
- Бронхит, пневмония, бронхопневмония және т. б.
- Бауырдың майлы азғындауы және майлы инфильтрациясы.
- Бауыр циррозы.
- Перитонид.
- Жаңа түзілістер.
Қорытынды
Пайдаланылған әдебиеттер тізімі
Кіріспе
Ветеринариялық-санитариялық сараптау ғылым реінде індеттанумен, параитологиямен, микробиологиямен, патологиялық анатомиямен, гистологиямен, биологиялық химиямен және ветеринариялық санитариямен тығыз байланысты. Осыған орай келесі пәндерді меңгермей ветеринариялық-сараптау бағдарламасын түсіну мүмкін емес десек те болады. Ветеринариялық-санитариялық сараптаудың негізгі міндеттері: тағам, жануарлар тектес техникалық және азық өнімдері арқылы тарайтын адамдар мен жауарларды індетті және инвазиялы аурулардан сақтандыру. Сонымен қоса ветеринариялық-санитариялық сараптау жануарлар мен олардың өнімдерінің жұқпалы емес ауруларын қарастарып ветеринариялық санитариялық баға береді. Осының ішіндегі қоян шаруашылық өнімінің жұқпалы емес ауруына тоқталып өтейін. Алдымен қоян өніміне, етіне бірден санитариялық бағасын бермей оның алдымен қандай шаруашылық екені жайлы жалпы оның етіне, өнімін түсіндіре отырайын. Сонымен, қоян шаруашылығы - қоян өсіріп, оның етін, терісін, түбітін өндіретін сала. Қоян еті нәрлі, шипалы тағам. Ет және тері үшін өсірілетін тұқымдары жылына 4 рет көжектейді, әр ретте орта есеппен 5 көжек табады. Көжектері тез жетілгіш 65 -70 күнде шағылыстыруға, 100-135 күнде союға жарайды (2-2, 5), яғни әр ұрғашы қояннан 20 көжек өсіріп, олардан 40-50 кг ет, 20 тері өндеуге болады. Қоянды 3 жыл шаруашылықта пайдаланады. Қазақстанда қоян өсірумен айналысу солтүстік облыстарда жолға қойылған. Қоянның негізінен үлкен ақ қоян, үлкен сұр қоян, шиншилла тұқымдары өсіріледі. Союға үй қояндары арнайы торкөздерге немесе жәшіктерге салынып әкелінеді. Сойысқа арнаған үй қояндарының дені сау, денесінде жарақат болмауы керек. Қыстыгүні туған көжектерге 3-4 айдан соң, ерте көктемде туғандарын 6-7 айлығында, ал күзгі кһжектерді қысқы жүні түсіп болған соң сояды. Үй қояндарын оюға қабылдау тәртібі ауыл шаруашылығы малдарын қабылдау тәртібіне ұқсас. Үй қояндары салынған тор көздер қабылдау үстелінің үстіне қойылады да, үй қояндары ветеринариялық тексеруден өткізіліп қондылығы анықталады, салмақтары өлшеніп іріктелінеді.
Жоғарыда айтылып кеткендей «сойысқа арнаған үй қояндарының дені сау, денесінде жарақат болмауы керек» - осыған орай жұқпалы емес аурулары кезінде сойысқа рұқсат етіле ме жоқ па?!, сойып қойған жағдайда олардың ұшасын, еттерін әрмен қарай не істейді, ветеринариялық-санитариялық бағасы қандай?! - дегендей сұрақтарға жауап бере, тақырыбымды аша отыра зерттейін!
І Негізгі бөлім
Өнімдерді вееринариялық-санитариялық сараптау
- Жарақаттар.
Жарақаттар алу себебі, этиологиясы:
Қояндарды күтіп-бағу кезінде және тасымалдау ережелері бұзылған кезде жарақаттануға жиі ұшырайды.
Жарақаттар түрлері :
- Қан құйылулар;
- Қанталаулар;
- Инфильтраттар;
- Жаралар;
- Сынықтар;
Өнімдерді ветеринариялық-санитариялық бағалау.
Жарақаттар жаңа болса, зақымдалған мүшелерді тазалап, ұшаны тағамға қолданады. Асқынулар боса, шешімді бактериоогиялық зерттеуден кейін қабылдайды, бактериологиялық зерттеу мүмкін болмаған жағдайда ұшаны жарамсыздыққа шығарады.


- Арықтау (жүдеу) .
Арықтау кезінде бұлшык ет ұлпасының дегенеративтік өзгерістері. Бұлшық ет семуі және май жиналатын мүшелерде іркілдек ісіктер байқалады.

Өнімдерді ветеринариялық-санитариялык бағалау.
- Арықтаудың себебіне қарамастан ұшаларды және мүшелерді утилдейді.

- Абсцесстер, флегмоналар, іріңді жаралар.
Қояндардың жұқпалы емес ауруларына абсцесс пен флегмона да жатды. Ал осы абсцесс пен флегмона патология жағынан іріңді қабынуға жатады. Абсцесс пен флегмонаның пайда болуы немесе процесстің жүру барысы: жалғақтың құрамыда лейкоциттер көп мөлшерде шоғырланып қалуына байланысты. Сол жердегі тірі және өлі лейкоциттер, макрофагтар, белокқа бай жалғақ, ыдыраған жергілікті ұлпа барлығы қосылып ірің құрайды. Ыдырау процесінде лейкоциттер майлы дистрофияға ұшырағандықтан, ірің сары түске енеді. Мінекей, осылайша іріңді қабыну екі түрге бөлінеді.
Біріншісі, Абсцесс (латынша Absceccus - бөлектену, оңашалану) деп сол жердегі ұлпаның некрозы әсерінен пайда болған шектеулі іріңді қабынуды атайды. Некрозға ұшыраған тоқымада көп мөлшерде лейкоциттер жиналады, олардың белокты ерітуші (протеолиттік) ферменттері өлі ұлпаны ыдыратып, іріңге толы қуыс пайда болад. Оның айналасы іріңді қабықпен (пиогенді мембрана) қоршалған. Алғашқыда ол көптеген майда капиллярлардан тұратын қабықпен қоршалады. Егер абсцесс ағзаның сыртқы қабатына жақын жайғасқан болса, ірің айналадағы тоқымаларға жайылып кетуі мүмкін, кейде жыланкөзденіп сыртқа ағып тұрады (свищ) .
Өнімдерді ветеринариялық-санитариялык бағалау.
Бірен-саран бітеу жаралар және жаралар кезінде, егер олардың мөлшері үлкен болмаса, оларды қоршап жатқан ұлпаларды домбығу болмаса және лимфа түйіндері өзгерісерге ұшырамаса, зақымдалған бөліктер мен ағзаларды жарамсыздыққа жатқызып, ұшаны шектеусіз босатады. Көптеген бітеу жаралар жеке мүшеерде табылса немесе бірен-саран жаралар мен аймақтық лимфа түйіндерінің өзгерістері және жайылған абсцесстер табылса, зақымдалған мүшелерді немесе ұлпаларды жарамсыздыққа шығарады, ал етті бактериологиялық зерттеу нәтижелеріне байланысты қолданады. Бауырдың бітеу жарасында бүкіл бауырды жарамсыздыққа шығарады, ал етті бактериологиялық әдіспен зерттейді. Бітеу жаралар лимфа түйіндерінде және бұлшық еттерде табылса, ұшаны техникалық утилизацияға жібереді.
Екіншісі, Флегмона (грек. phlegmone -өрт) - жайылған іріңді қабыну. Флегмона пайда болғанда жалғақ ағзаның барлық қабаттарына бірдей сіңіп, оны некрозға ұшыратады немесе ісіндетеді. Некрозға үшыраған флегмона қатты флегмона деп аталады. Ірің тоқымаға бойлай сіңген болса, жұмсақ флегмна деп аталады. Флегмона көбінесе тері асты және шырышты қабық астындағы шелде кездеседі. Егер ірің дененің табиғи қуытарына жиналып қалса, ол эмпиема деп аталады. Олардың түрлеріне плевра эмпиемасы, өт қалтасының эмпиемасы жатады.
Ф легмона - бұл жайылып, тарауға бейім қауіпті үрдіс, бұнда іріңдетуші бактериялар зақымдалған мүшелерден баска мүшелер мен ұлпаларға тез тарайды. Іріңді үрдіспен асқынған жаралар - іріңдетуші микрофлораның көбею (таралу) көрсеткіші болып табылады.
Сонымен флегмона түрлері:
- Қатты флегмона
- Жұмсақ флегмна
- Эмпиема
Плевра эмпиемасы Өт қалтасының эмпиемасы
Өнімдерді ветеринариялық-санитариялык бағалау.
Ұшаны шектеусіз босатады егер (зақымданған бөліктер мен ағзаларды жарамсыздыкқа жатқызып) :
- Бірен-саран бітеу жаралар;
- Жара мөлшері үлкен емес;
- Қоршап жатқан ұлпаларда домбығу жоқ;
- Лимфа түйіндері өзгерістерге ұшырамаған.
Бактериологиялық зерттеу нәтижелеріне байланысты ұшаны босату :
- Көптеген бітеу жаралар;
- Аймақтық лимфа түйіндерінің өзгерістері бар;
- Жайылған флегмоналар табылған.
- Гидремия.
Гидремия - бұлшык ет және дәнекер ұлпаларында, дене қуыстарында көп мөлшерде транссудаттың жиналуы.
Сойғаннан кейіңгі диагностикасы:
- Тері асты клетчаткасында, бұлшық еттерде сұйықтық жиналады.
- Бұлшық еттер болбыр, сулы болады.
- Жамбас қуысында, бүйрек маңында жиналған майлар азаяды.
- Майлардың орнында іркілдек масса пайда болады.
Өнімдерді ветеринариялық-санитариялык бағалау.
- Гидремия белгілері айқын болған жағдайда ұша мен мүшелерді техннкалық утилизацияға жібереді.
- Егер белгілері әлсіз болып, бір тәулік ұстағаннан кейін жоғалып кетсе және де бактериологиялық зерттеу нәтижелері теріс болса ұшаны шектеусіз босатуға болады.

- Уремия.
Уремия - бүйрек аурулары немесе бүйректін зәр шығару қызметінің бұзылып, зәр шығару түтіктерінің бітелуі нәтижесінде болатын несептін құрамдас бөліктерінің өнімдерімен организмнің өзіндік улану үрдісі.
Патогенезі: Қалыпты жағдайда бүйрек арқылы несеппен шығарылатын, зат алмасу өнімдерімен организмнің аутоуыттануы:
- қалдық азоттың құрамбөлшектері
- азоттық (аммиак, креатинин, несеп қышқылы, зәрнәсіл ж. б. ) қалдықтарме
- аминқышқылдары метаболизмі (фенол, скатол, индол) ж. б.
Өнімдерімен су - электролиттер алмасуының бұзылуы:
- гипоосмолялдық гипергидратация = сумен улану;
- гиперкалиемия, гипермагниемия, гипокәлциемия, гипонатриемия, гиперфосфатемия, гиперсульфатемия;
- метаболизмдік ацидоз (биокарбонаттар кері сіңірілуінің бұзылуы, сутегі иондары шығарылуының төмендеуі) ;
- гормондар, витаминдер (вит. Д) метаболизмінің бұзылуы, эритропоэтиндер, простагландиндер, кининдер ж. б. түзілуінің бұзылуы.
Ұшаны қансыздандыру кезіндегі өзгерістер:
Қансыздандыру кезінде қанда несеп иісі болады. Тері асты және бұлшық еттер аралық дәнекер ұлпа несеп иісі бар сұйыққа толы, кейде қан кұйылулар болады. Қуық жыртылған кезде, несеп құрсақ қуысына жиналады. Уремия кезінде несеп және аммиактың иісі бүкіл ұшаан шығып тұрады, қайнатқан кезе иіс күшейеді.
Өнімдерді ветеринариялық-санитариялык бағалау.
Уремиямен ауырған кояннаң алынған барлық сойыс өнімдерін утилизацияға жібереді.
- Сары ауру.
Сары ауру - патологиялық жағдай. Әр түрлi аурулардан пайда болған қан өт пигментiне асып-толған нәтижеде тканьдер сары түске боялғанымен сипатталады.
Майлы тканнiң боялуы каротин қабаттану нәтижесiнде (азықтан болған сары түс), сондай-ақ кәрi малдарда (жасына қарай болған сары ауру) пайда болуы мүмкін.
Сойылғаннан кейiнгi диагностика.
Май, сiрi қабаттар, фассциялар, ал кей жағыдайларда бұлшық ет те сары немесе сары-жасыл түске боялған. Лимфа түйiндерi кесiмде сары түстi, ал басқанда лимфа сары-жасыл немесе қызғылт сары түстi болады.
Ұлпалардың сары түске боялуының себептері:
- өт жолдарының бітелуі,
- лептоспироз,
- салмонеллез,
- бауыр аурулары және т. б ауруларға байланысты.
Бұл кезде тұрақты сары түске боялу барлық ұлпаларда байқалады - майда, бұлшық етте, сіңірлерде байкалады. Лимфа түйіндері сарғыш түсті, басқан кезде сары-жасыл немесе қызғылт-сары түсті лимфа бөлінеді. Бірақ қояндарда ұлпалардың сары түске боялуы жаз кезінде каротин мен каротиноидтapғa бай жасыл шөп жеген кезде, сонымен қатар рациондарында зығыр және рапс күнжарасы болған кезде болуы мүмкін екенін ескеру кажет.
Өнімдерді ветеринариялық-санитариялык бағалау.
Сары түс 2 күн арасында кетпейтiн болса ұша мен iшкi мүшелердi утилдейдi. Сары түс кеткен жағдайда санитарлық бағаны бактериологиалық зерттеу нәтижесiне қарап қояды. Азық және жасына қарай болған сары ауруға ұшыраған еттi кедергiсiз жiбередi.
Ұлпалардың 48 сағат өткеннен кейін де жоғалмайтын сары түске боялуы кезінде және қайнатқан кезде ащы дәм және нәжістің иісі болады, ұшаны техникалық утилизацияға жібереді. Егер жағымсыз иісі және ащы дәмі болмаса, сары түс 48 сағаттан соң жоғалып кетсе, ет бактериологиялық зерттеу нәтижелеріне байланысты босатады. Сары түске боялудың себебі азықтандыруға байланысты олса, ұшаларды шектеусіз босатады.
- Бронхит, пневмония, бронхопневмония және т. б.
Жұқпалы емес этиологиялы бұл аурулар көбіне көжектерде кездеседі. Бұл аурулардың себебі көбіне қояндарды не олардың көжектерін ылғалды суық қораларда, өтпелі желде, цемент еденде ұстағаннаң, зеңденген азықпен азықтандырғаннан болады. Бронхит кезінде бронхтарда және кеңірдекте сұйык немесе көпіршікті экссудат табылады, кілегейлі қабыгы қызыл түсті, домбыққан, катаральды және катаральды - геморрагиялық қабынуға ұшыраған. Бронхопневмония кезінде бронхтардағы өзгерістермен қатар, өкпенің барлық бөлігінде немесе жеке бөлігінде тығыздалған ошақтар табылады. Бронхиалды және аралық перде лимфа түйіндері шырынды, ұлғайған болуы мүмкін, канталаулар кездеседі. Плеврит кезінде косталды және өкпе плеврасының түсі өзгерген, плеврада фибринозды экссудат табылады. Сойыс өнімдерін дұрыс санитариялық тұрғыдан бағалау үшін жұқпалы этнологиялы аурулардан ажырату кажет.
Тыныс жолы ауруларының туу себебi: салқын тию, ыстық ауа, жарақат, химиялық заттар, қоян азығында өсетiн зеңдіген саңырауқұлақтар, кейбiр инфекциялық аурулар болады. Осы жағыдайларды тыныс жолдарының әртүрлi микрофлоралармен зақымдануы байқалады.
Сойылғаннан кейiнгi диагностика . Мұрынның клегей қабаты, кеңiрдек қызарған, үсiген кей кезде сұйық немесе көпiршектi экссудаты бар, катаралдық немесе катаралдық - геморрагиялық iсiктiң ошақтары болады. Бронхопневмонияда кеңiрдекте және өкпеде тығыз бөлшектер болады, кесiмде сұр-қызыл түстi (гепатизация) . Көкiрек қуысының лимфа түйiндерi сулы, үлкейген, қанталаған. Плевра жарақатталған жағдайда фибриоздық экссудат, қосылу (спайка) байқалады.
Өнімдерді ветеринариялық-санитариялық бағалау.
- Барлық ауруларда өкпені жартылай немесе түгелдей жарамсыздыққа шығарады.
- Жұқпалы емес ошақты пневмония кезінде, егер бронхиалды және перде аралық лимфа түйіндерінде және плеврада өзгерістер болмаса, барлық сойыс өнімдерін (өкпеден басқа) шектеусіз босатады.
- Егер аймақтық лимфа түйіндерінің айқын өзгерістері болып, плеврит және плевропневмония табылса, онда сойыс өнімдерін қолдануды бактериологиялық зерттеуден кейін шешеді. Сонымен қатар аспирацияның (бітелу) кез келген түрінде өкпе жарамсыздыққа шығарылады.
- Бауырдың майлы азғындауы және майлы инфильтрациясы.
Бауырдың майлы азғындауы улану, індет және инфекция нәтижесінде пайда болады, бұл кезде бауыр сары, сұрғылт-сары, сарғыш-қоныр түске боялады. Тілгенде ұлпасы тұтқыр, ұлпасы болбыр, жиектері калыңдаған. Бауырдың майлы азғындауы көбіне физиологиялық құбылыс болып табылады және азыкты көп мөлшерде бергеннен пайда болады. Бауырдың түсі сарғыш, бірақ ұлпасы серпімді, тілгенде жылтыр болады.
Өнімдерді ветеринариялық-санитариялық бағалау.
Майлы азғындау кезінде бауырды қайнатылған шұжық немесе консерві дайындауға жібереді. Майлы азғындау кезінде бауырды утилдейді, ал ұшадан ет сынамасын алып, салмонеллезге тексергеннен кейін етті қолдану жайында шешім қабылданады.
- Бауыр церрозы
- Іс жүргізу
- Автоматтандыру, Техника
- Алғашқы әскери дайындық
- Астрономия
- Ауыл шаруашылығы
- Банк ісі
- Бизнесті бағалау
- Биология
- Бухгалтерлік іс
- Валеология
- Ветеринария
- География
- Геология, Геофизика, Геодезия
- Дін
- Ет, сүт, шарап өнімдері
- Жалпы тарих
- Жер кадастрі, Жылжымайтын мүлік
- Журналистика
- Информатика
- Кеден ісі
- Маркетинг
- Математика, Геометрия
- Медицина
- Мемлекеттік басқару
- Менеджмент
- Мұнай, Газ
- Мұрағат ісі
- Мәдениеттану
- ОБЖ (Основы безопасности жизнедеятельности)
- Педагогика
- Полиграфия
- Психология
- Салық
- Саясаттану
- Сақтандыру
- Сертификаттау, стандарттау
- Социология, Демография
- Спорт
- Статистика
- Тілтану, Филология
- Тарихи тұлғалар
- Тау-кен ісі
- Транспорт
- Туризм
- Физика
- Философия
- Халықаралық қатынастар
- Химия
- Экология, Қоршаған ортаны қорғау
- Экономика
- Экономикалық география
- Электротехника
- Қазақстан тарихы
- Қаржы
- Құрылыс
- Құқық, Криминалистика
- Әдебиет
- Өнер, музыка
- Өнеркәсіп, Өндіріс
Қазақ тілінде жазылған рефераттар, курстық жұмыстар, дипломдық жұмыстар бойынша біздің қор #1 болып табылады.



Ақпарат
Қосымша
Email: info@stud.kz